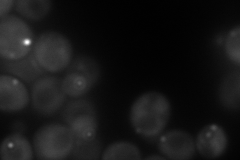
YJL044C

View description
GTPase-activating protein (GAP) for the yeast Rab family member, Ypt6p; involved in vesicle mediated protein transport
Localization:
Intensity:
Fold change:
Significance:
-
C’ GFP library in SD

below threshold14.5 -
N' NOP1pr-GFP in SD

cytosol,punctate103.603 -
N' TEF2pr-mCherry in SD
cytosol,punctate142.445 -
N' NATIVEpr-GFP in SD

punctate21.4628 -
N' TEF2pr-VC and Cyto-VN in SD

cytosol,punctate52.2978 -
C’ GFP library in SD+DTT

cytosol16.871.16No -
C’ GFP library in SD+H2O2

cytosol15.81.08No -
C’ GFP library in Starvation Media

cytosol16.191.11No -
C’ GFP library on the background of Pup2-DaMP

below threshold -
C’ GFP library on the background of CCT mutant

below threshold16.23931.1189No
